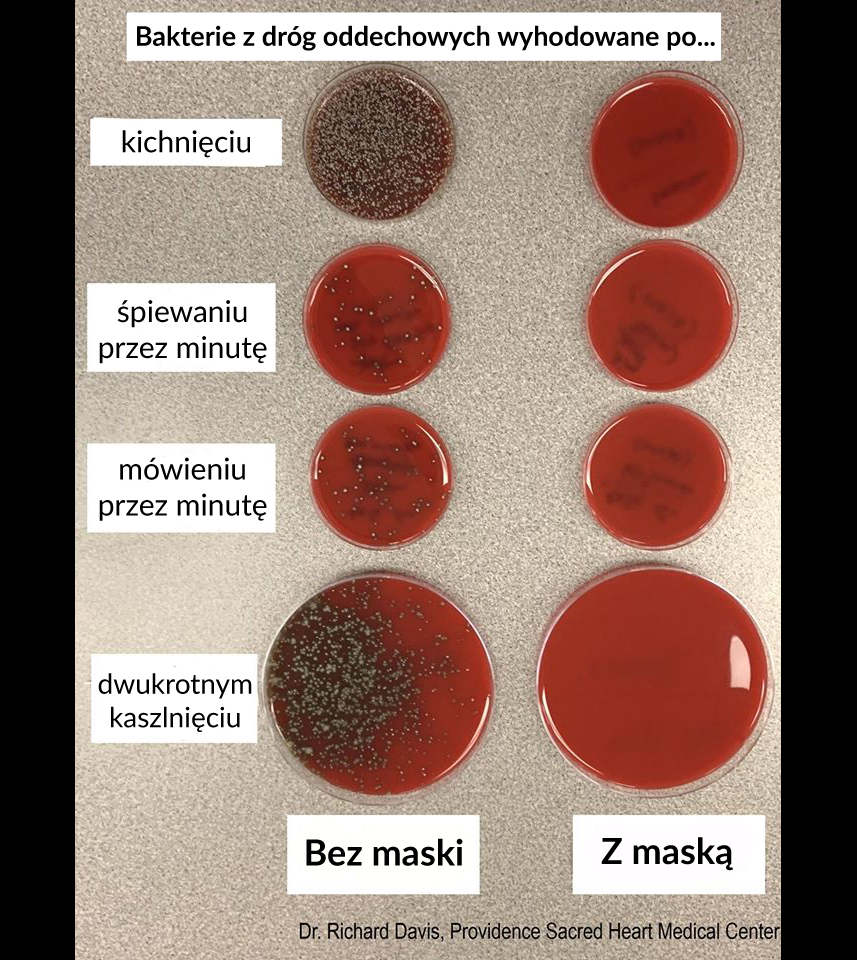
Hodowle bakterii wyhodowanych po poszczególnych czynnościach wykonanych z maską i bez maski.

Ela Weronika 🌈
@elaweronika
kobieta, żona, mama, pełna chaosu, ale od niego wszystko się zaczyna.
ID: 250685856
11-02-2011 16:01:37
164 Tweet
26 Takipçi
82 Takip Edilen




Giereczkowo.pl zbiera na pomoc dla Mai. Pokażmy że polskie giereczkowo potrafi. siepomaga.pl/giereczkowo-pl przez Siepomaga.pl Prosimy o RT


Obserwuję wszystkich kandydatów na prezydenta kraju, w którym żyję ja i moja rodzina. Najbliższe poglądy mam z panem Szymon Hołownia i trzymam kciuki żeby właśnie on reprezentował nasz kraj.



Oficjalnie: Jako wyborca Szymon Hołownia w 2. turze zagłosuję na Rafał Trzaskowski! Proszę o to samo pozostałych z ponad 2,5 miliona wyborców Szymona, bo mamy szansę odbić prezydenturę PiS-owi, a potem są większe szanse na nowy ruch obywatelski! #Hołownia2020